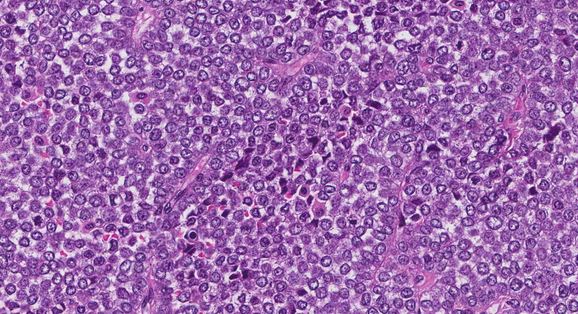
nut

Αλέξανδρος Νικολαΐδης: Η σπάνια μoρφή καρκίνου από την οποία έπασχε
«Η σπάνια μορφή καρκίνου στον πνεύμονα διεγνώσθη σε μεταστατικό στάδιο» λέει ο γιατρός του
Μία τραγική είδηση έγινε γνωστή το πρωί της Παρασκευής. Ο Αλέξανδρος Νικολαϊδης, δις αργυρός Ολυμπιονίκης του Τάε Κβον Ντο άφησε την τελευταία του πνοή σε ηλικία 43 ετών. Ο Αλέξανδρος Νικολαϊδης, πάλεψε επί δυο χρόνια με μια εξαιρετικά σπάνια μορφή καρκίνου.
Στην τελευταία συγκλονιστική ανάρτηση που ανέβηκε στο προφίλ του, ο Αλέξανδρος Νικολαΐδης «περιέγραφε» τον αγώνα που έδωσε με τον καρκίνο, ένα σπάνιο τύπο καρκίνου, το καρκίνωμα nut.
Τι είναι το καρκίνωμα NUT;
Το καρκίνωμα NUT είναι ένας επιθετικός τύπος καρκίνου που ορίζεται από την παρουσία μιας γενετικής αλλαγής που περιλαμβάνει ένα γονίδιο που ονομάζεται NUTM1. Αυτός ο όγκος μπορεί να εμφανιστεί οπουδήποτε κατά μήκος της μέσης γραμμής του σώματος, συμπεριλαμβανομένου του θώρακα, του μεσοθωρακίου, του πνεύμονα, της ρινικής κοιλότητας και των παραρρινίων κόλπων.
Τι προκαλεί το καρκίνωμα NUT;
Προς το παρόν, οι γιατροί δεν γνωρίζουν τι προκαλεί το καρκίνωμα NUT.
Πώς γίνεται η διάγνωση του καρκινώματος NUT;
Η διάγνωση του NUT γίνεται συνήθως αφού αφαιρεθεί ένα μικρό δείγμα ιστού σε μια διαδικασία που ονομάζεται βιοψία. Η διάγνωση μπορεί επίσης να γίνει μετά την αφαίρεση ολόκληρου του όγκου σε μια διαδικασία που ονομάζεται εκτομή. Στη συνέχεια, ο ιστός αποστέλλεται σε έναν παθολόγο που τον εξετάζει στο μικροσκόπιο.
Πώς φαίνεται το καρκίνωμα NUT στο μικροσκόπιο;
Όταν εξετάζεται στο μικροσκόπιο, ο όγκος αποτελείται από κύτταρα με μεγάλους, στρογγυλούς, ανοιχτούς πυρήνες. Το γενετικό υλικό στο εσωτερικό του πυρήνας μπορεί να περιγραφεί ως φυσαλιδώδες και μεγάλες συστάδες γενετικού υλικού που ονομάζονται πυρήνες παρατηρούνται συχνά. Οι παθολόγοι συχνά περιγράφουν τα κύτταρα του όγκου ως μονότονα επειδή όλα τα κύτταρα μοιάζουν πολύ μεταξύ τους. Η διαίρεση των καρκινικών κυττάρων που ονομάζεται μιτωτικές μορφές και ένα είδος κυτταρικού θανάτου που ονομάζεται νέκρωση φαίνονται χαρακτηριστικά. Μερικά από τα καρκινικά κύτταρα μπορεί να παράγουν μια πρωτεΐνη που ονομάζεται κερατίνη που βρίσκεται συνήθως σε εξειδικευμένα πλακώδη κύτταρα. Οι παθολόγοι το περιγράφουν ως κερατινοποίηση και στο καρκίνωμα NUT αυτή η διαδικασία τείνει να είναι «απότομη» ή χωρίς καμία μετάβαση από τα μη κερατινοποιητικά κύτταρα όγκου.
Ποιες άλλες εξετάσεις μπορούν να γίνουν για να επιβεβαιωθεί η διάγνωση του καρκινώματος NUT;
Η διάγνωση του NUT απαιτεί επιβεβαίωση μιας γενετικής αλλοίωσης που περιλαμβάνει το γονίδιο NUTM1. Η αλλαγή έχει ως αποτέλεσμα το γονίδιο NUTM1 να συνδυάζεται με ένα άλλο γονίδιο (συνήθως BRD4 ή BRD3) για να σχηματίσει ένα νέο γονίδιο που ονομάζεται γονίδιο σύντηξης. Οι δοκιμές που μπορούν να χρησιμοποιηθούν για τον εντοπισμό αυτής της γενετικής αλλαγής περιλαμβάνουν υβριδισμός in situ φθορισμού (FISH), αλληλούχιση επόμενης γενιάς (NGS) ή αλυσιδωτή αντίδραση πολυμεράσης (RT-PCR).
Οι παθολόγοι μπορεί να κάνουν μια άλλη εξέταση που ονομάζεται ανοσοϊστοχημεία για επιβεβαίωση της διάγνωσης. Όταν εκτελούνται, τα καρκινικά κύτταρα στο καρκίνωμα NUT είναι συνήθως θετικά για p40, p63 και κυτταροκερατίνες. Όταν εκτελούνται, τα καρκινικά κύτταρα είναι πάντα θετικά για πρωτεΐνη NUT.
Άλλα χαρακτηριστικά που μπορεί να περιλαμβάνονται στην αναφορά παθολογίας σας
Περινευρική εισβολή
Τα νεύρα είναι σαν μακριά σύρματα που αποτελούνται από ομάδες κυττάρων που ονομάζονται νευρώνες. Τα νεύρα βρίσκονται σε όλο το σώμα και είναι υπεύθυνα για την αποστολή πληροφοριών (όπως θερμοκρασία, πίεση και πόνο) μεταξύ του σώματός σας και του εγκεφάλου σας. Η περινευρική εισβολή είναι ένας όρος που χρησιμοποιούν οι παθολόγοι για να περιγράψουν κύτταρα όγκου που συνδέονται με ένα νεύρο. Η περινευρική εισβολή είναι σημαντική επειδή τα καρκινικά κύτταρα μπορούν να χρησιμοποιήσουν το νεύρο για να εξαπλωθούν στους περιβάλλοντες ιστούς. Αυτό αυξάνει τον κίνδυνο ο όγκος να αναπτυχθεί εκ νέου μετά τη θεραπεία.

Λεμφαγγειακή εισβολή
Το αίμα κινείται γύρω από το σώμα μέσω μακριών λεπτών σωλήνων που ονομάζονται αιμοφόρα αγγεία. Ένας άλλος τύπος υγρού που ονομάζεται λέμφος που περιέχει απόβλητα και κύτταρα του ανοσοποιητικού συστήματος κινείται γύρω από το σώμα μέσω εξειδικευμένων αγγείων που ονομάζονται λεμφαγγεία. Ο όρος λεμφαγγειακή εισβολή χρησιμοποιείται για να περιγράψει κύτταρα όγκου που βρίσκονται μέσα σε ένα αίμα ή λεμφικό αγγείο. Η λεμφαγγειακή εισβολή είναι σημαντική γιατί αυτά τα κύτταρα είναι σε θέση μεταστάσεις (εξάπλωση) σε άλλα μέρη του σώματος όπως π.χ λεμφαδένες ή τους πνεύμονες. Η λεμφαγγειακή εισβολή είναι πολύ συχνή στο καρκίνωμα NUT.

Περιθώρια
A περιθώριο είναι κάθε ιστός που κόπηκε από τον χειρουργό προκειμένου να αφαιρεθεί ο όγκος από το σώμα σας. Όποτε είναι δυνατόν, οι χειρουργοί θα προσπαθήσουν να κόψουν ιστό έξω από τον όγκο για να μειώσουν τον κίνδυνο τυχόν καρκινικών κυττάρων να μείνουν πίσω μετά την αφαίρεση του όγκου.
Οι τύποι των περιθωρίων που περιγράφονται στην αναφορά σας θα εξαρτηθούν από το πού ξεκίνησε ο όγκος και τον τύπο της χειρουργικής επέμβασης. Τα περιθώρια συνήθως περιγράφονται στην αναφορά σας μόνο αφού αφαιρεθεί ολόκληρος ο όγκος.
Ένα αρνητικό περιθώριο σημαίνει ότι δεν παρατηρήθηκαν κύτταρα όγκου σε κανένα από τα κομμένα άκρα του ιστού. Ένα περιθώριο ονομάζεται θετικό όταν υπάρχουν καρκινικά κύτταρα στην ίδια την άκρη του κομμένου ιστού. Ένα θετικό περιθώριο σχετίζεται με υψηλότερο κίνδυνο επανεμφάνισης του όγκου στο ίδιο σημείο μετά τη θεραπεία.
Επειδή το καρκίνωμα NUT συχνά αφαιρείται σε πολλά κομμάτια, ο παθολόγος μπορεί να μην είναι σε θέση να αξιολογήσει αξιόπιστα τα όρια του όγκου. Για αυτόν τον λόγο, οι περισσότερες αναφορές παθολογίας για το καρκίνωμα NUT δεν έχουν πληροφορίες σχετικά με τα όρια.
Λεμφαδένες
Λεμφαδένες είναι μικρά ανοσολογικά όργανα που βρίσκονται σε όλο το σώμα. Τα καρκινικά κύτταρα μπορούν να ταξιδέψουν από τον όγκο σε έναν λεμφαδένα μέσω των λεμφικών καναλιών που βρίσκονται μέσα και γύρω από τον όγκο. Η κίνηση των καρκινικών κυττάρων από τον όγκο σε έναν λεμφαδένα ονομάζεται μετάσταση.
Ο παθολόγος θα εξετάσει προσεκτικά κάθε λεμφαδένα για κύτταρα όγκου. Οι λεμφαδένες που περιέχουν κύτταρα όγκου ονομάζονται συχνά θετικοί ενώ εκείνοι που δεν περιέχουν κύτταρα όγκου ονομάζονται αρνητικοί. Οι περισσότερες αναφορές περιλαμβάνουν τον συνολικό αριθμό των λεμφαδένων που εξετάστηκαν και τον αριθμό, εάν υπάρχει, που περιέχουν κύτταρα όγκου.
Καταθέσεις όγκου
Μια ομάδα καρκινικών κυττάρων στο εσωτερικό του α λεμφαδένας ονομάζεται a κατάθεση όγκου. Εάν εντοπιστεί κατάθεση όγκου, ο παθολόγος σας θα μετρήσει την εναπόθεση και η μεγαλύτερη απόθεση όγκου που βρέθηκε θα περιγραφεί στην αναφορά σας. Οι μεγαλύτερες εναποθέσεις όγκου συνδέονται με χειρότερο πρόγνωση. Το μέγεθος της μεγαλύτερης κατάθεσης όγκου χρησιμοποιείται επίσης για τον προσδιορισμό του κομβικού σταδίου.
Με πληροφορίες από την ιστοσελίδα www.mypathologyreport.ca/el/
«Η σπάνια μορφή καρκίνου στον πνεύμονα διεγνώσθη σε μεταστατικό στάδιο» λέει ο γιατρός του
Ο πρύτανης του Πανεπιστημίου Αθηνών, κ. Αθανάσιος Δημόπουλος μίλησε στη Σταματίνα Τσιμτσιλή και το Happy Day για τον αθλητή που πάλεψε γενναία μέχρι την τελευταία στιγμή.
«Είναι μία ιδιαίτερα δυσάρεστη ημέρα. Τα ειλικρινή μας συλλυπητήρια στην οικογένεια του Αλέξανδρου για τη συμπαράσταση που του έδειξαν στην προσπάθεια αυτή και τον αγώνα που έκανε για 2 χρόνια για τον καρκίνο και να έχουν δύναμη να τον θυμούνται και να τιμούν τη μνήμη του.
Όντως, διαγνώσθηκε με μία πολύ σπάνια μορφή καρκίνου του πνεύμονα σε προχωρημένο ήδη στάδιο από την περίοδο της διάγνωσης. Αντιμετωπίστηκε με όλες τις ενδεδειγμένες θεραπευτικές αγωγές, ωφελήθηκε από αυτές για κάποιο χρονικό διάστημα, αλλά δυστυχώς ότι διαγνώστηκε με τη νόσο σε μεταστατικό στάδιο δεν του έδωσε τη δυνατότητα να το ξεπεράσει» είπε ο κ. Δημόπουλος, ο οποίος βρισκόταν όλο αυτό το διάστημα στο πλευρό του Αλέξανδρου Νικολαΐδη.
«Όντας παθολόγος, ογκολόγος και ερχόμενος καθημερινά σε επαφή με ασθενείς που πάσχουν από καρκίνο, προφανώς είναι μία δύσκολη περίοδος ειδικά όταν αφορούν νέα άτομα, ειδικά όταν αυτά αισθάνονται το βάρος της οικογένειας, των μικρών παιδιών, τον φόβο ότι μπορεί να τα αφήσουν πίσω, χωρίς να έχουν βοηθήσει στην ολοκλήρωση των σπουδών τους και στην αποκατάστασή τους, δημιουργεί ένα επιπλέον άγχος. Γι’ αυτό και οι λίγοι μήνες παράτασης ζωής να έχουν σημασία, ακόμη και ψυχολογική γι’ αυτούς» πρόσθεσε ο πρύτανης του ΕΚΠΑ.
Όπως τόνισε στο Happy Day ο κ. Δημόπουλος, ο Αλέξανδρος Νικολαΐδης έλαβε όλα τα ενδεδειγμένα φάρμακα.
Δείτε επίσης:
Πέθανε ο Ολυμπιονίκης Αλέξανδρος Νικολαΐδης, στα 42 του χρόνια
Αποχαιρέτησε τον Αλέξανδρό της με το "Μονόγραμμα" του Ελύτη
Συλλυπητήρια μηνύματα για την απώλεια του Αλέξανδρου Νικολαΐδη
Αλέξανδρος Νικολαΐδης: Οι διακρίσεις, οι γάμοι και η πολιτική καριέρα
- Οργανωμένο κύκλωμα «δείχνουν» οι καταθέσεις της 12χρονης – Λέξη προς λέξη το μαρτύριο του παιδιού
- Μήνυμα από το 112 για επικίνδυνα καιρικά φαινόμενα
- Αλέξανδρος Νικολαΐδης: Οι διακρίσεις, οι γάμοι και η πολιτική καριέρα




